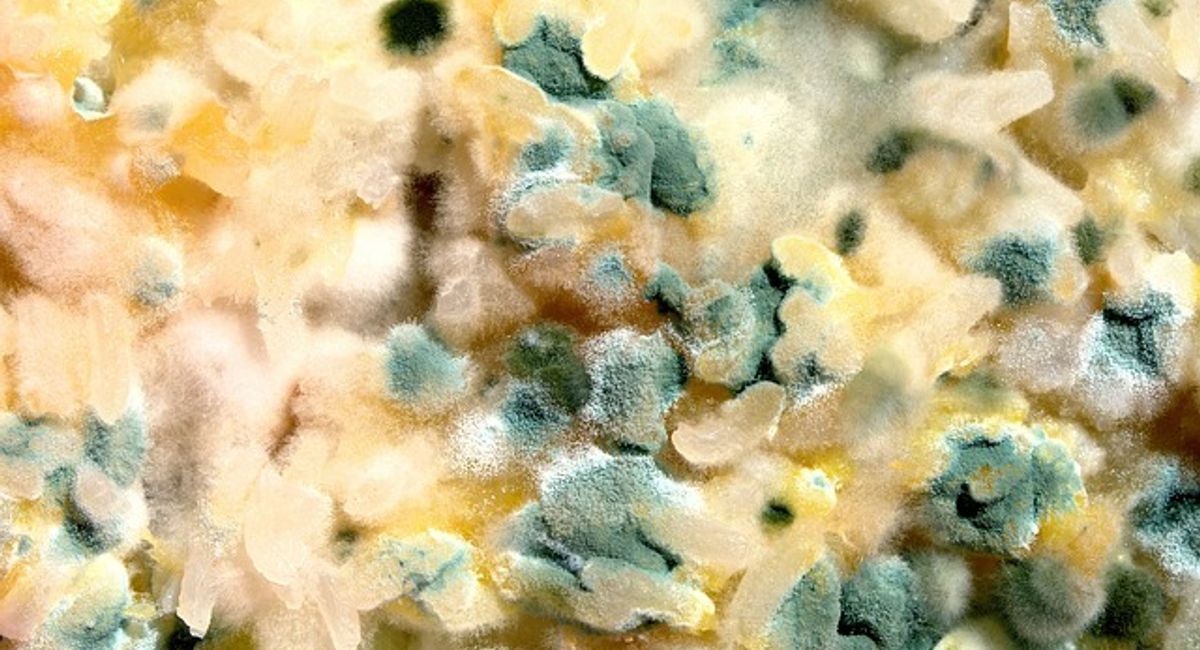
Image

October 9th
National Moldy Cheese Day
A cheesemonger is a person who specializes in cheeses, butter, and other dairy products. They may take offense at the common person’s offense of moldy cheese. Well, depending on the type of mold of course. Some cheese molds, red or brown tinged molds, for example, are offensive. Toss those bacteria contaminated moldy cheeses in the garbage quickly and move along to the grey, blue or green colored moldy cheeses in the fridge instead.